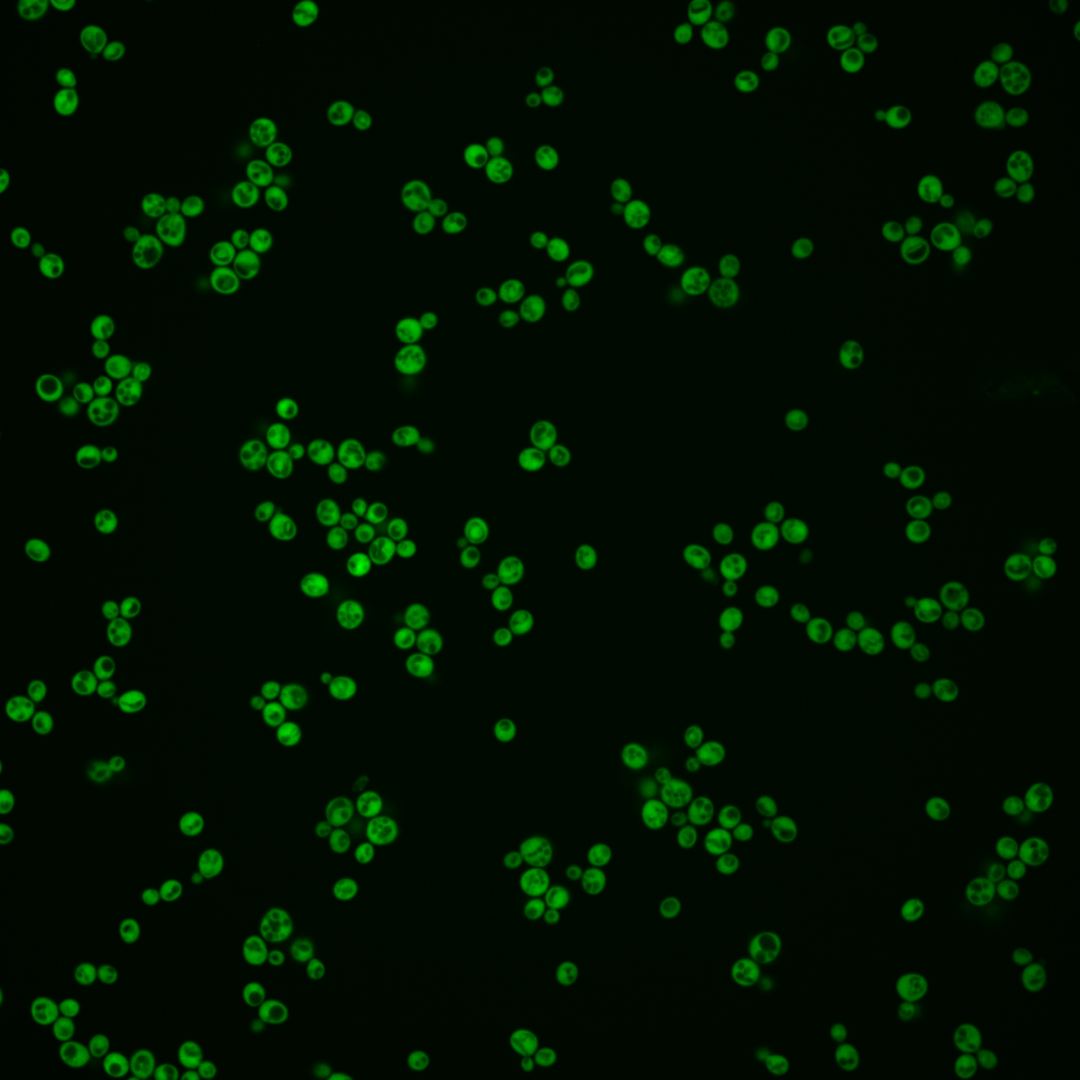
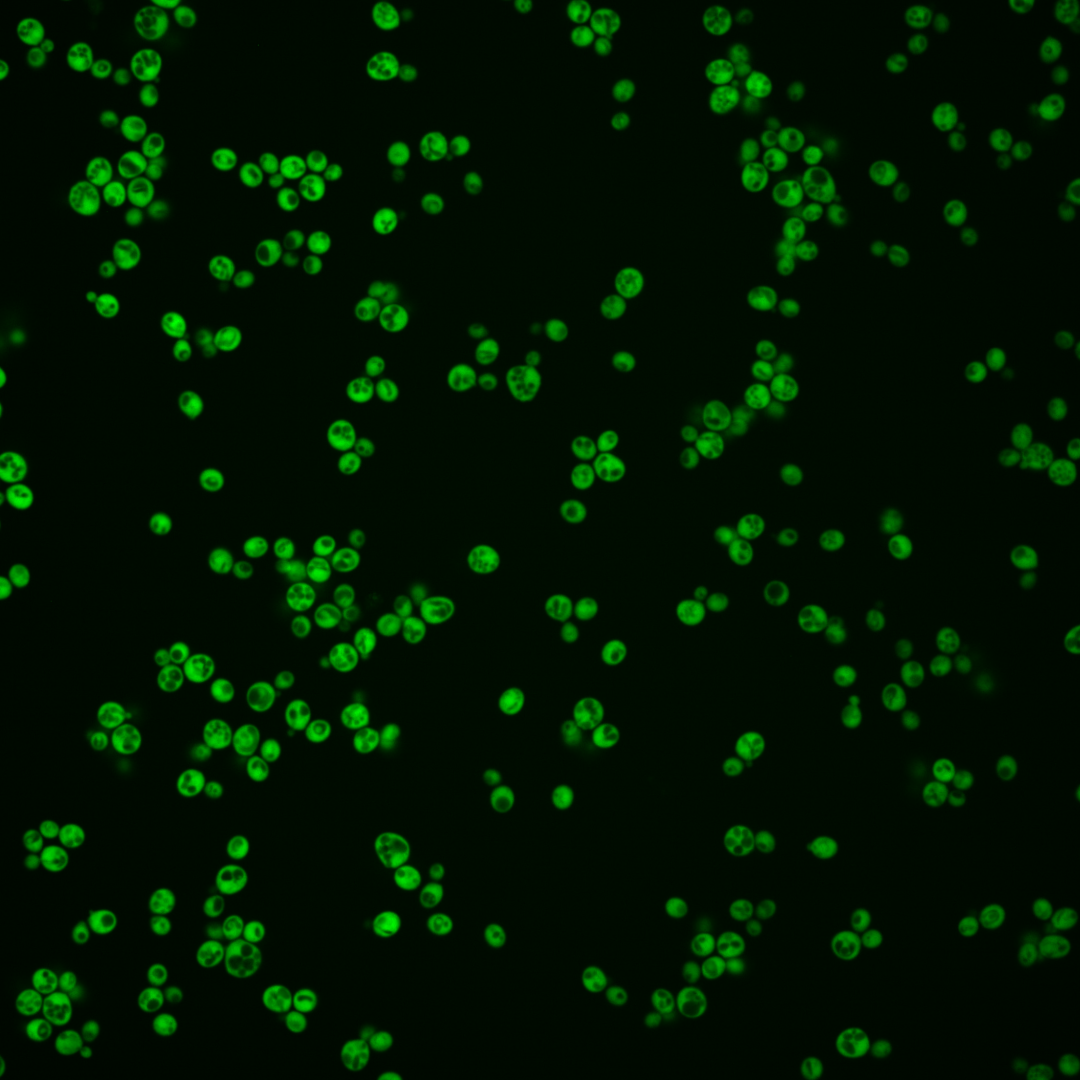
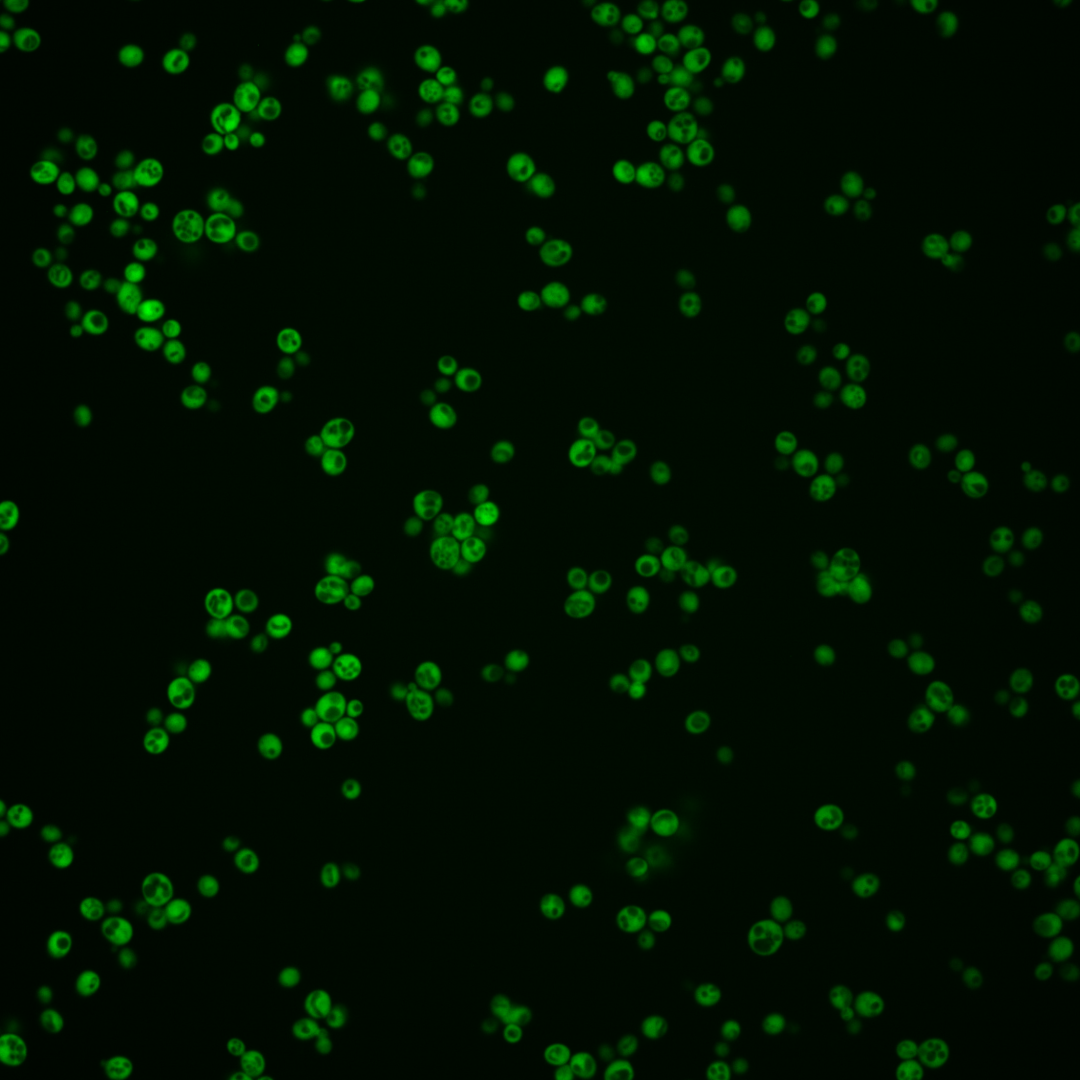
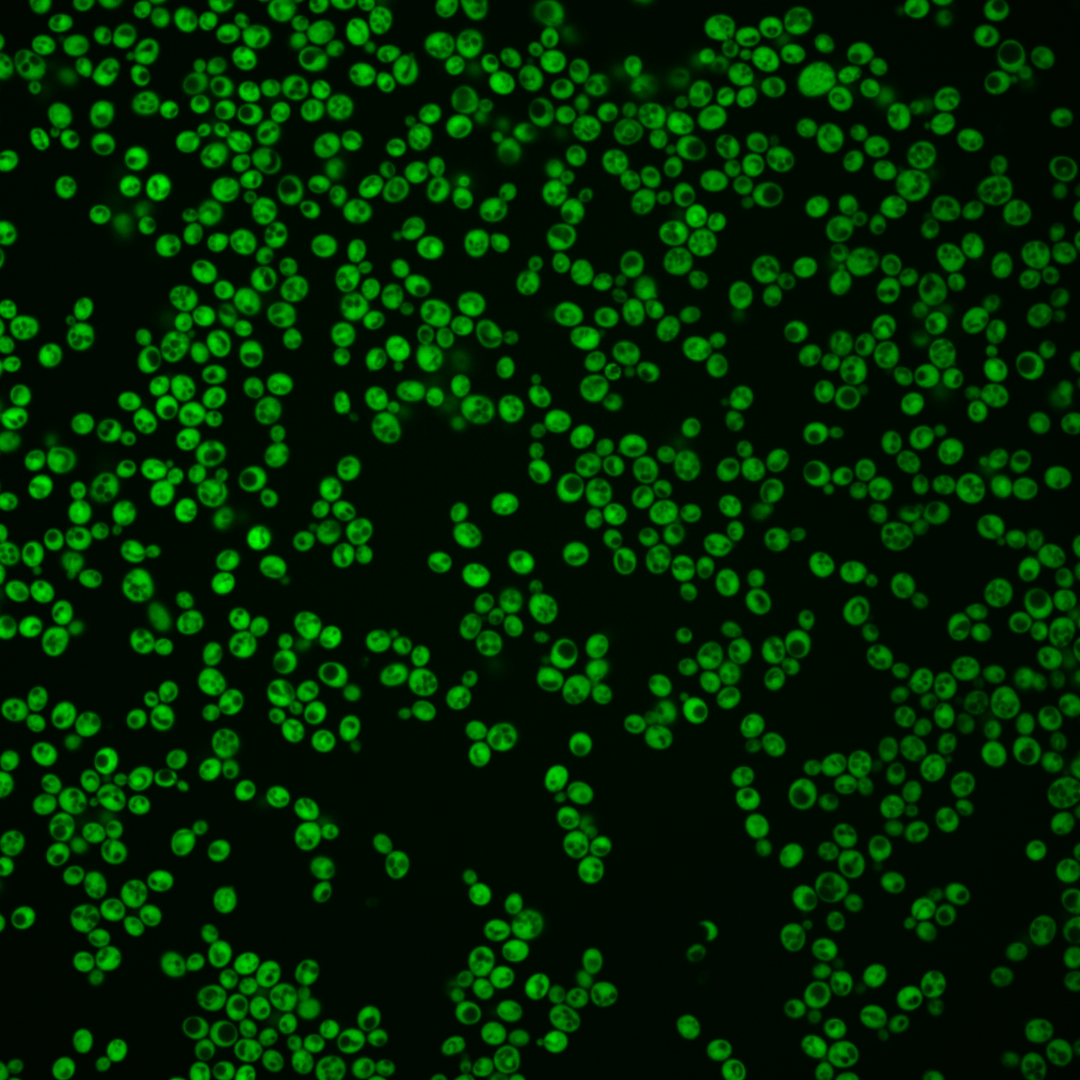
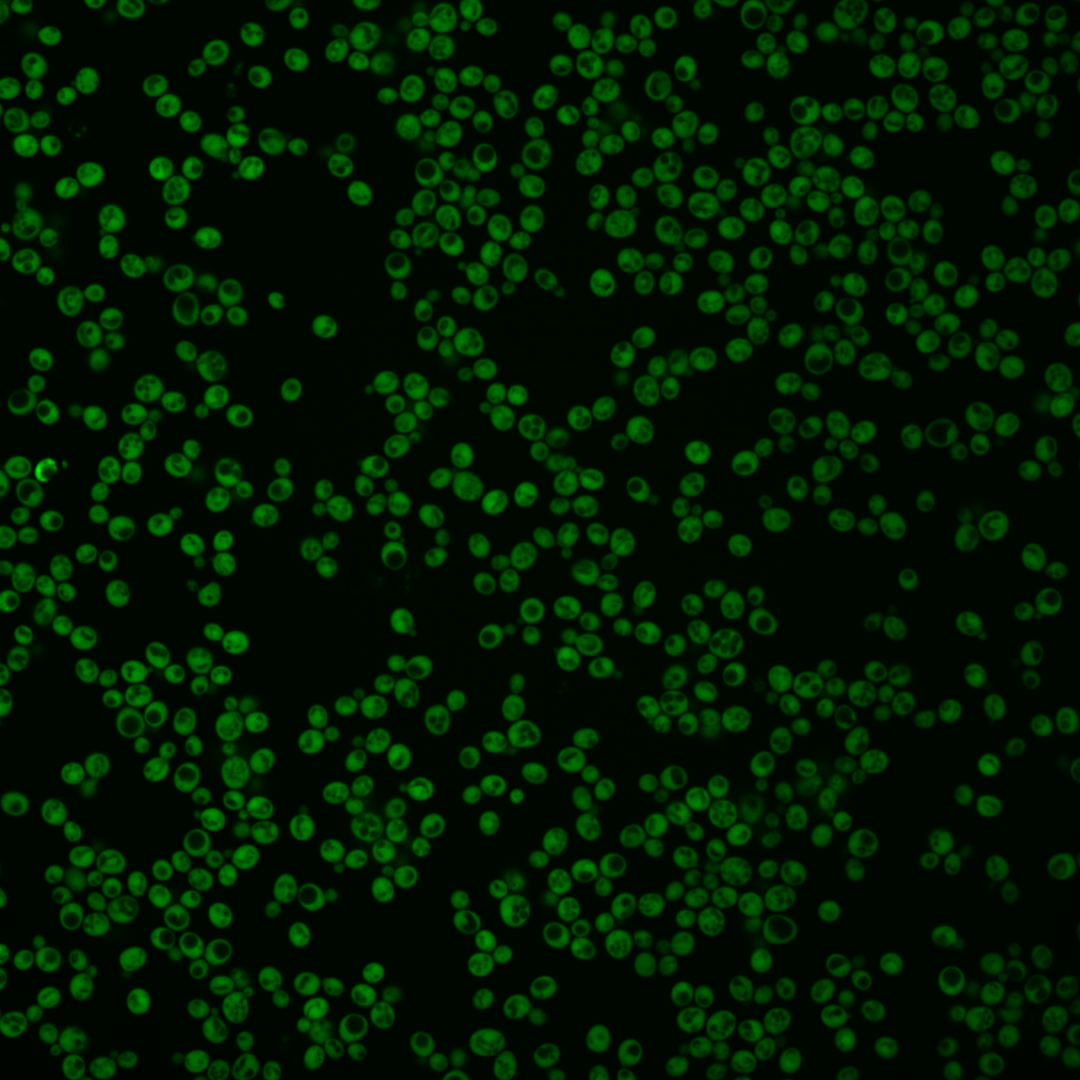
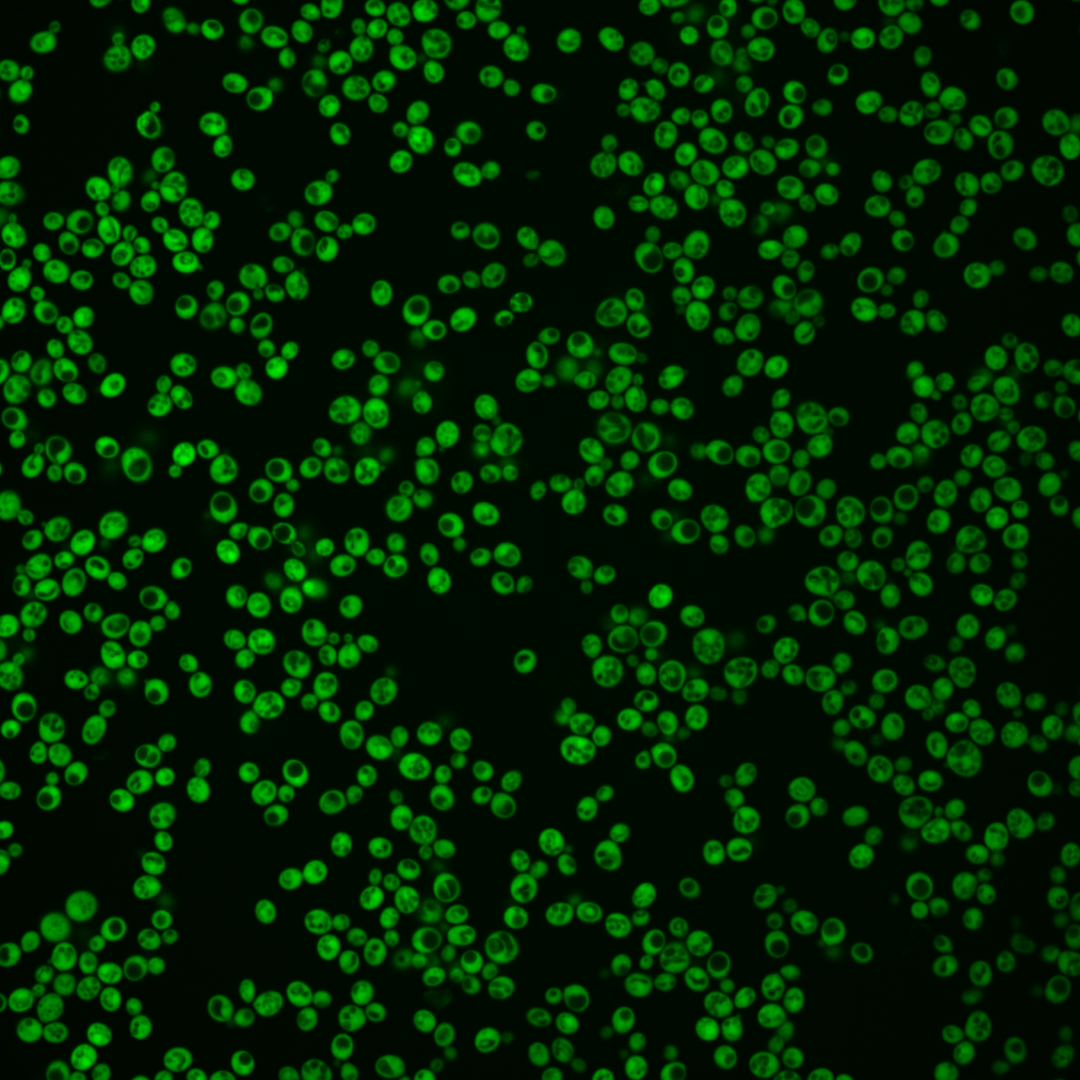
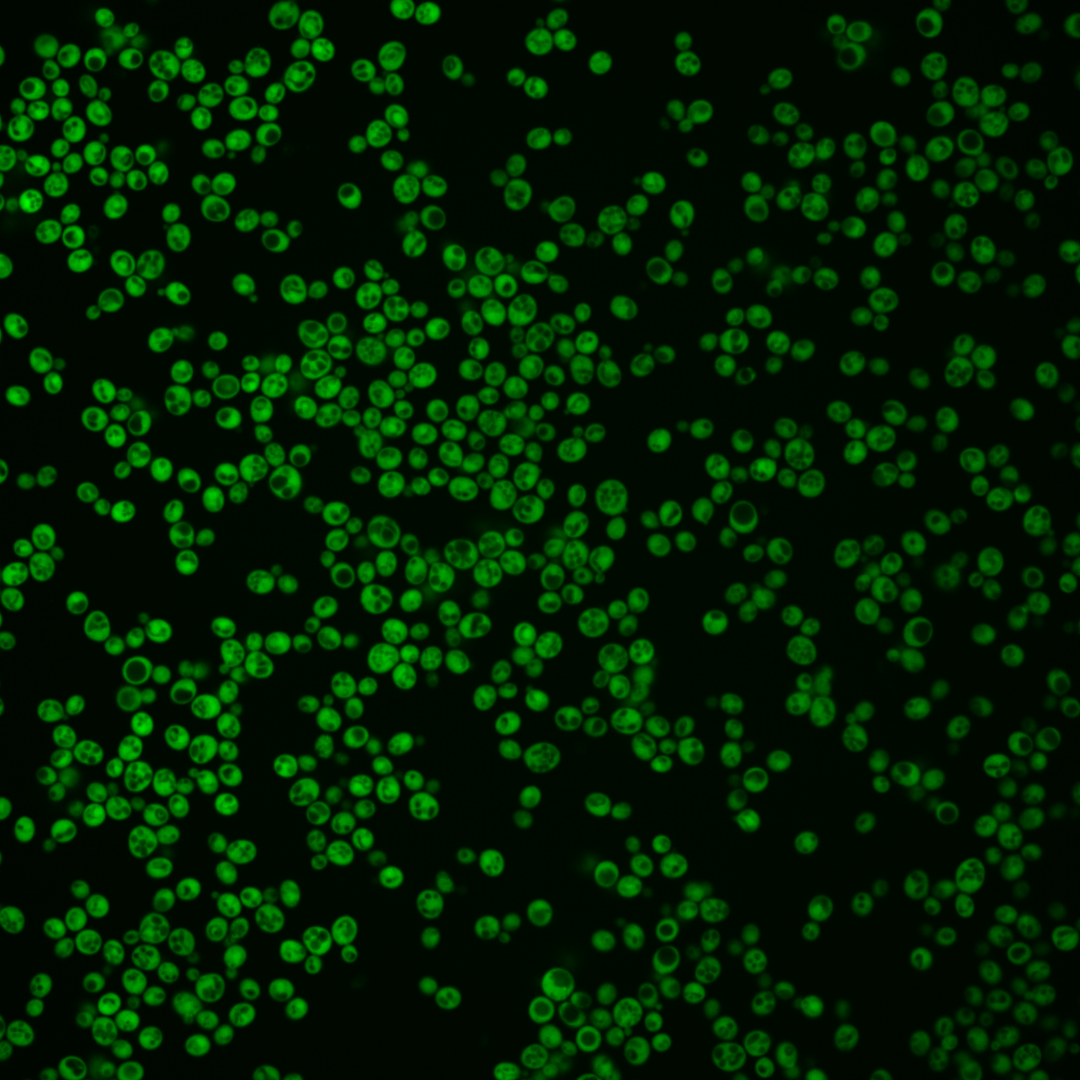

| Standard name | |
|---|---|
| Human Ortholog | |
| Description | Dihydroorotate dehydrogenase; catalyzes the fourth enzymatic step in the de novo biosynthesis of pyrimidines, converting dihydroorotic acid into orotic acid |
Micrographs




















































































Sub-cellular Localization
Yeast GFP Assignment
Protein Abundance
Localization Change
External localization resources
| ensLOC | DeepLoc | |||||||||||||||||||||||
|---|---|---|---|---|---|---|---|---|---|---|---|---|---|---|---|---|---|---|---|---|---|---|---|---|
| Localization | WT1 | WT2 | WT3 | RAP60 | RAP140 | RAP220 | RAP300 | RAP380 | RAP460 | RAP540 | RAP620 | RAP700 | HU80 | HU120 | HU160 | rpd3Δ_1 | rpd3Δ_2 | rpd3Δ_3 | WT1 | WT2 | WT3 | AF100 | AF140 | AF180 |
| Cortical Patches | 0 | 0 | 0 | 0 | 0 | 0 | 2 | 2 | 4 | 4 | 2 | 9 | 0 | 0 | 0 | 0 | 0 | 0 | 0 | 0 | 0 | 0 | 0 | 0 |
| Bud | 0 | 0 | 0 | 0 | 3 | 0 | 0 | 2 | 3 | 3 | 1 | 1 | 0 | 0 | 2 | 0 | 0 | 0 | 0 | 0 | 0 | 2 | 3 | 6 |
| Bud Neck | 0 | 0 | 0 | 0 | 0 | 0 | 0 | 0 | 0 | 0 | 0 | 0 | 0 | 0 | 0 | 0 | 0 | 0 | 0 | 0 | 0 | 0 | 0 | 0 |
| Bud Site | 0 | 0 | 0 | 0 | 0 | 0 | 0 | 0 | 0 | 0 | 0 | 0 | 0 | 0 | 0 | 0 | 0 | 0 | – | – | – | – | – | – |
| Cell Periphery | 0 | 0 | 2 | 2 | 3 | 4 | 9 | 8 | 15 | 8 | 2 | 16 | 1 | 4 | 3 | 3 | 2 | 2 | 0 | 0 | 0 | 0 | 0 | 0 |
| Cytoplasm | 120 | 160 | 106 | 198 | 390 | 272 | 343 | 307 | 261 | 284 | 204 | 291 | 397 | 519 | 553 | 246 | 139 | 219 | 117 | 146 | 109 | 239 | 380 | 435 |
| Endoplasmic Reticulum | 0 | 2 | 0 | 0 | 6 | 6 | 24 | 26 | 15 | 22 | 3 | 27 | 4 | 0 | 3 | 7 | 6 | 8 | 0 | 0 | 1 | 0 | 1 | 2 |
| Endosome | 0 | 0 | 0 | 0 | 0 | 0 | 0 | 0 | 0 | 0 | 0 | 0 | 1 | 0 | 0 | 0 | 1 | 2 | 0 | 0 | 0 | 0 | 0 | 0 |
| Golgi | 0 | 0 | 0 | 0 | 1 | 0 | 0 | 0 | 0 | 0 | 0 | 0 | 0 | 0 | 0 | 0 | 0 | 0 | 0 | 0 | 0 | 0 | 0 | 0 |
| Mitochondria | 0 | 0 | 0 | 0 | 0 | 0 | 0 | 3 | 8 | 8 | 17 | 10 | 0 | 0 | 0 | 2 | 1 | 2 | 0 | 0 | 1 | 0 | 0 | 1 |
| Nucleus | 1 | 1 | 1 | 1 | 2 | 2 | 6 | 9 | 8 | 2 | 2 | 5 | 1 | 1 | 0 | 2 | 0 | 2 | 0 | 1 | 1 | 2 | 6 | 2 |
| Nuclear Periphery | 0 | 0 | 0 | 0 | 0 | 0 | 0 | 0 | 0 | 0 | 0 | 0 | 0 | 0 | 0 | 0 | 0 | 0 | 0 | 0 | 0 | 0 | 0 | 0 |
| Nucleolus | 0 | 0 | 0 | 0 | 0 | 0 | 0 | 0 | 0 | 0 | 0 | 0 | 0 | 0 | 0 | 1 | 0 | 0 | 0 | 0 | 0 | 0 | 0 | 0 |
| Peroxisomes | 0 | 0 | 0 | 0 | 0 | 0 | 0 | 0 | 0 | 0 | 0 | 0 | 0 | 0 | 0 | 0 | 1 | 0 | 0 | 0 | 0 | 0 | 0 | 0 |
| SpindlePole | 0 | 0 | 0 | 0 | 0 | 0 | 0 | 0 | 0 | 0 | 0 | 0 | 0 | 0 | 0 | 0 | 0 | 0 | 0 | 0 | 0 | 0 | 0 | 0 |
| Vac/Vac Membrane | 0 | 0 | 1 | 1 | 1 | 5 | 8 | 23 | 9 | 37 | 16 | 42 | 1 | 1 | 0 | 4 | 1 | 0 | 0 | 0 | 0 | 0 | 3 | 4 |
| Unique Cell Count | 121 | 162 | 109 | 199 | 397 | 285 | 383 | 366 | 301 | 350 | 239 | 373 | 403 | 519 | 556 | 254 | 142 | 223 | 121 | 152 | 117 | 249 | 402 | 458 |
| Labelled Cell Count | 121 | 163 | 110 | 202 | 406 | 289 | 392 | 380 | 323 | 368 | 247 | 401 | 405 | 525 | 561 | 265 | 151 | 235 | 121 | 152 | 117 | 249 | 402 | 458 |
Yeast GFP Assignment
Protein Abundance
| Screen | WT1 | WT2 | WT3 | RAP60 | RAP140 | RAP220 | RAP300 | RAP380 | RAP460 | RAP540 | RAP620 | RAP700 | HU80 | HU120 | HU160 | rpd3Δ_1 | rpd3Δ_2 | rpd3Δ_3 | AF100 | AF140 | AF180 |
|---|---|---|---|---|---|---|---|---|---|---|---|---|---|---|---|---|---|---|---|---|---|
| Mean Cell GFP Intensity (1e-4) | 41.6 | 58.8 | 35.8 | 41.2 | 32.8 | 25.4 | 21.8 | 19.4 | 17.6 | 15.5 | 15.1 | 15.5 | 45.6 | 46.0 | 44.4 | 52.0 | 55.8 | 52.2 | 49.1 | 48.1 | 50.3 |
| Std Deviation (1e-4) | 9.7 | 13.0 | 9.9 | 9.4 | 7.4 | 5.9 | 5.4 | 4.7 | 4.5 | 3.8 | 3.9 | 3.4 | 11.4 | 9.5 | 8.8 | 19.1 | 16.2 | 16.9 | 13.5 | 12.6 | 12.8 |
| Intensity Change (Log2) | – | – | – | 0.2 | -0.13 | -0.49 | -0.72 | -0.89 | -1.03 | -1.21 | -1.25 | -1.21 | 0.35 | 0.36 | 0.31 | 0.54 | 0.64 | 0.54 | 0.45 | 0.43 | 0.49 |
Localization Change
| Localization | RAP60 | RAP140 | RAP220 | RAP300 | RAP380 | RAP460 | RAP540 | RAP620 | RAP700 | HU80 | HU120 | HU160 | rpd3Δ_1 | rpd3Δ_2 | rpd3Δ_3 |
|---|---|---|---|---|---|---|---|---|---|---|---|---|---|---|---|
| Cortical Patches | 0 | 0 | 0 | 0 | 0 | 0 | 0 | 0 | 0 | 0 | 0 | 0 | 0 | 0 | 0 |
| Bud | 0 | 0 | 0 | 0 | 0 | 0 | 0 | 0 | 0 | 0 | 0 | 0 | 0 | 0 | 0 |
| Bud Neck | 0 | 0 | 0 | 0 | 0 | 0 | 0 | 0 | 0 | 0 | 0 | 0 | 0 | 0 | 0 |
| Bud Site | 0 | 0 | 0 | 0 | 0 | 0 | 0 | 0 | 0 | 0 | 0 | 0 | 0 | 0 | 0 |
| Cell Periphery | 0 | 0 | 0 | 0 | 0 | 0 | 0 | 0 | 0 | 0 | 0 | 0 | 0 | 0 | 0 |
| Cytoplasm | 1.7 | 0.7 | -0.8 | -2.5 | -3.6 | -3.1 | -4.1 | -3.3 | -4.6 | 0.9 | 3.8 | 2.2 | -0.2 | 0.3 | 0.6 |
| Endoplasmic Reticulum | 0 | 0 | 0 | 2.7 | 2.9 | 0 | 2.7 | 0 | 2.9 | 0 | 0 | 0 | 0 | 0 | 0 |
| Endosome | 0 | 0 | 0 | 0 | 0 | 0 | 0 | 0 | 0 | 0 | 0 | 0 | 0 | 0 | 0 |
| Golgi | 0 | 0 | 0 | 0 | 0 | 0 | 0 | 0 | 0 | 0 | 0 | 0 | 0 | 0 | 0 |
| Mitochondria | 0 | 0 | 0 | 0 | 0 | 0 | 0 | 2.9 | 0 | 0 | 0 | 0 | 0 | 0 | 0 |
| Nucleus | 0 | 0 | 0 | 0 | 0 | 0 | 0 | 0 | 0 | 0 | 0 | 0 | 0 | 0 | 0 |
| Nuclear Periphery | 0 | 0 | 0 | 0 | 0 | 0 | 0 | 0 | 0 | 0 | 0 | 0 | 0 | 0 | 0 |
| Nucleolus | 0 | 0 | 0 | 0 | 0 | 0 | 0 | 0 | 0 | 0 | 0 | 0 | 0 | 0 | 0 |
| Peroxisomes | 0 | 0 | 0 | 0 | 0 | 0 | 0 | 0 | 0 | 0 | 0 | 0 | 0 | 0 | 0 |
| SpindlePole | 0 | 0 | 0 | 0 | 0 | 0 | 0 | 0 | 0 | 0 | 0 | 0 | 0 | 0 | 0 |
| Vacuole | 0 | 0 | 0 | 0 | 2.2 | 0 | 3.2 | 2.3 | 3.3 | 0 | 0 | 0 | 0 | 0 | 0 |
External localization resources
Images






























Protein Concentration and Protein Localization Data
| R1 | R2 | R3 | ||||||||||||||||
|---|---|---|---|---|---|---|---|---|---|---|---|---|---|---|---|---|---|---|
| G1 Pre-START | G1 Post-START | S/G2 | Metaphase | Anaphase | Telophase | G1 Pre-START | G1 Post-START | S/G2 | Metaphase | Anaphase | Telophase | G1 Pre-START | G1 Post-START | S/G2 | Metaphase | Anaphase | Telophase | |
| Concentration | 37.5696 | 43.8819 | 42.32 | 37.2242 | 34.9684 | 40.4433 | 44.5849 | 57.8814 | 50.456 | 48.487 | 43.8486 | 52.2524 | 51.8888 | 56.6271 | 55.4229 | 51.6244 | 54.2262 | 53.5632 |
| Actin | 0.0009 | 0.0001 | 0.0001 | 0.0004 | 0.0005 | 0.0001 | 0.0088 | 0 | 0.0029 | 0.0184 | 0.0012 | 0.0001 | 0.0001 | 0.0001 | 0 | 0 | 0 | 0.0001 |
| Bud | 0.0002 | 0.0001 | 0 | 0.0012 | 0.0002 | 0 | 0.0009 | 0 | 0.0021 | 0 | 0.0009 | 0.0001 | 0 | 0 | 0 | 0 | 0 | 0 |
| Bud Neck | 0.0002 | 0.0001 | 0.0002 | 0.0002 | 0.0004 | 0.0005 | 0.0004 | 0.0001 | 0.0007 | 0.0001 | 0.0005 | 0.0003 | 0.0001 | 0.0001 | 0.0001 | 0.0002 | 0.0001 | 0.0003 |
| Bud Periphery | 0.0001 | 0 | 0 | 0.0005 | 0.0004 | 0 | 0.0005 | 0 | 0.0017 | 0 | 0.0004 | 0 | 0 | 0 | 0 | 0 | 0 | 0 |
| Bud Site | 0.0001 | 0 | 0 | 0.0001 | 0.0009 | 0 | 0.0012 | 0 | 0.0047 | 0 | 0.0005 | 0 | 0 | 0 | 0 | 0 | 0 | 0 |
| Cell Periphery | 0.0001 | 0 | 0 | 0.0001 | 0.001 | 0 | 0.0002 | 0 | 0.0003 | 0 | 0.0002 | 0 | 0 | 0 | 0 | 0 | 0 | 0 |
| Cytoplasm | 0.941 | 0.9841 | 0.9823 | 0.9502 | 0.8701 | 0.9666 | 0.8568 | 0.9952 | 0.9269 | 0.9053 | 0.8234 | 0.9844 | 0.9629 | 0.9953 | 0.9872 | 0.9854 | 0.9918 | 0.982 |
| Cytoplasmic Foci | 0.0023 | 0.0003 | 0.0002 | 0.0086 | 0.0141 | 0.0002 | 0.0206 | 0.0001 | 0.0088 | 0.0028 | 0.026 | 0.0003 | 0.0001 | 0.0001 | 0.0001 | 0.0001 | 0.0001 | 0.0002 |
| Eisosomes | 0 | 0 | 0 | 0 | 0.0004 | 0 | 0.0001 | 0 | 0 | 0 | 0 | 0 | 0 | 0 | 0 | 0 | 0 | 0 |
| Endoplasmic Reticulum | 0.001 | 0.0004 | 0.0004 | 0.0008 | 0.0023 | 0.0007 | 0.0014 | 0.0004 | 0.0028 | 0.0001 | 0.0018 | 0.0005 | 0.0005 | 0.0001 | 0.0002 | 0.0002 | 0.0001 | 0.0003 |
| Endosome | 0.001 | 0 | 0.0001 | 0.0027 | 0.007 | 0.0001 | 0.0286 | 0 | 0.007 | 0.0001 | 0.0094 | 0.0002 | 0.0001 | 0 | 0 | 0 | 0 | 0.0001 |
| Golgi | 0.0003 | 0 | 0 | 0.0003 | 0.0014 | 0 | 0.0085 | 0 | 0.003 | 0.0005 | 0.0013 | 0 | 0 | 0 | 0 | 0 | 0 | 0 |
| Lipid Particles | 0.0019 | 0 | 0 | 0.0005 | 0.0224 | 0 | 0.01 | 0 | 0.0021 | 0.0003 | 0.0027 | 0 | 0 | 0 | 0 | 0 | 0 | 0 |
| Mitochondria | 0.0005 | 0 | 0 | 0.0046 | 0.0149 | 0 | 0.0132 | 0 | 0.0126 | 0.0001 | 0.0559 | 0.0001 | 0.0001 | 0 | 0 | 0 | 0 | 0 |
| None | 0.001 | 0.0002 | 0.0002 | 0.0034 | 0.0095 | 0.0001 | 0.0023 | 0.0001 | 0.0037 | 0.0001 | 0.0045 | 0.0002 | 0.0002 | 0.0001 | 0.0001 | 0.0001 | 0.0001 | 0.0001 |
| Nuclear Periphery | 0.007 | 0.002 | 0.0027 | 0.0042 | 0.0094 | 0.0051 | 0.0034 | 0.0005 | 0.0018 | 0.0008 | 0.0056 | 0.0022 | 0.0057 | 0.0007 | 0.0014 | 0.0028 | 0.0008 | 0.0019 |
| Nucleolus | 0.0002 | 0 | 0 | 0.0006 | 0.0049 | 0 | 0.0016 | 0 | 0.001 | 0 | 0.0044 | 0 | 0 | 0 | 0 | 0 | 0 | 0 |
| Nucleus | 0.0363 | 0.0121 | 0.0136 | 0.0144 | 0.0245 | 0.026 | 0.0159 | 0.0036 | 0.0088 | 0.01 | 0.0291 | 0.0107 | 0.0289 | 0.0033 | 0.0107 | 0.011 | 0.0067 | 0.0147 |
| Peroxisomes | 0.0031 | 0 | 0 | 0.0005 | 0.0012 | 0 | 0.0141 | 0 | 0.0015 | 0.061 | 0.0013 | 0 | 0 | 0 | 0 | 0 | 0 | 0 |
| Punctate Nuclear | 0.0009 | 0.0001 | 0.0001 | 0.0007 | 0.0038 | 0.0001 | 0.0017 | 0 | 0.0006 | 0.0001 | 0.0093 | 0.0001 | 0.0001 | 0 | 0.0001 | 0.0001 | 0.0001 | 0.0001 |
| Vacuole | 0.0016 | 0.0002 | 0.0002 | 0.0034 | 0.0072 | 0.0004 | 0.0072 | 0.0001 | 0.0048 | 0.0001 | 0.0115 | 0.0006 | 0.0008 | 0.0001 | 0.0001 | 0.0002 | 0.0001 | 0.0002 |
| Vacuole Periphery | 0.0004 | 0 | 0 | 0.0028 | 0.0036 | 0.0001 | 0.0024 | 0 | 0.0021 | 0 | 0.0099 | 0.0002 | 0.0003 | 0 | 0 | 0.0001 | 0 | 0.0001 |
Sequencing Data
| R1 | R2 | |||||||||
|---|---|---|---|---|---|---|---|---|---|---|
| G1 Post-START | S/G2 | Metaphase | Anaphase | Telophase | G1 Post-START | S/G2 | Metaphase | Anaphase | Telophase | |
| Gene Expression | 96.329 | 93.9406 | 58.09 | 72.6962 | 77.9646 | 49.013 | 69.3905 | 55.2035 | 51.8684 | 86.4728 |
| Translational Efficiency | 2.0814 | 1.888 | 2.4421 | 1.5269 | 1.9364 | 3.2465 | 2.1136 | 1.9841 | 1.7655 | 1.9049 |
Hit Data
| Dataset | Hit |
|---|---|
| Protein Concentration | ✘ |
| Protein Localization | ✘ |
| Gene Expression | ✘ |
| Translational Efficiency | ✘ |
Endocytosis
| Temp | Actin Patch (Sac6-tdTomato) | Cortical Patch (Sla1-GFP) | Late Endosome (Snf7-GFP) | Vacuole (Vph1-GFP) |
|---|---|---|---|---|
| 37℃ | ||||
| RT |
Cell Cycle Omics
CYCLoPs (Ura1-GFP)
| Gene / Allele | Actin Patch (Sac6-tdTomato) | Cortical Patch (Sla1-GFP) | Late Endosome (Snf7-GFP) | Vacuole (Sac6-tdTomato) |
|---|
| Gene | Images |
|---|
| Gene | Images |
|---|
Images are not yet available
Images are not yet available